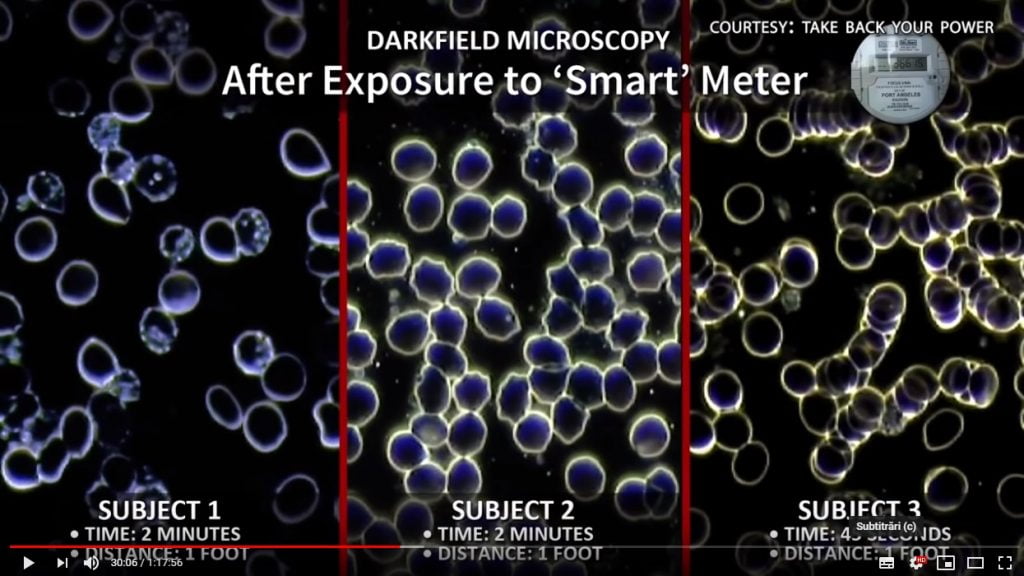
pericolele radiatiilor antenelor

Există dovezi copleșitoare care pot dovedi falsificarea documentelor guvernamentale oficiale pentru a justifica un regulament care autorizează o tehnologie periculoasă pentru sănătate.
Proliferarea micro-antenelor celulare de generația a patra (4G) și în curând 5G provoacă o tulburare în rândul populației din lumea întreagă. Acest lucru este susținut de rezultatele studiilor recente pe animale care au determinat recent consilierii Internațional de Cercetare în Domeniul Cancerului să recomande o reevaluare urgentă a efectelor undelor electromagnetice emise de antenele de telefonie, clasificate ca fiind „posibil cancerigene“, în 2011.
Radiațiile ionizante sunt, în general, considerate a avea suficientă energie pentru a rupe legăturile covalente în ADN, dar, de fapt, cea mai mare parte a pagubelor se datorează stresului oxidativ care duce la un exces de radicali liberi.
Videoclipul de mai jos analizează potențialele pericole ale expunerii prelungite la emisiile de frecvențe radio (RF) de la antene și alte tehnologii fără fir, în special pentru sănătatea și dezvoltarea copiilor. Acesta evaluează legăturile acestora cu cancerul de sân și creier, infertilitatea crescută, mutațiile genetice legate de autism și ADHD, precum și alte probleme de sănătate care apar în era globală din cauza dispozitivelor fără fir, inclusiv hipersensibilitatea electromagnetică (EHS).
Astăzi, nivelul de expunere la radiațiile cu microunde pulsate de la tehnologiile fără fir este în creștere exponențială, în timp ce standardele de siguranță stabilite de autoritățile federale de reglementare sunt depășite. Tipul de câmpuri electromagnetice emise de telefonul dvs. mobil este cuprins între 2 și 5 gigahertz. Noile dispozitive fără fir, cum ar fi telefoanele inteligente, tablete, routere Wi-Fi și monitoarele pentru copii și milioane de produse cu cipuri/antene și care participă la dezvoltarea „Internetul Obiectelor (“Internet of Things”)“, continuă să fie lansate chiar dacă emit constant radiații cu microunde la niveluri care pot deteriora mitocondrii. Prea puțin se face pentru a asigura siguranța și conștientizarea publicului.
Luați o mică pauză și vizionați acest videoclip șocant care dovedește falsificarea documentelor guvernamentale:
Notă* Pentru a traduce filmul în limba română, faceți clic pe opțiunea “Subtitrări (C)”, faceți clip pe roată, selectați opțiunea “Traducere automată” și alegeți limba.
https://www.youtube.com/watch?v=ol3tAxnNccY&feature=youtu.be